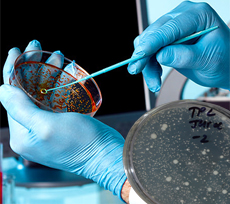
Microbiology Testing

TESTING SERVICES
Call Us : +91-11- 40522000/41611000
Spectro Analytical Labs Pvt. Limited provides reliable and precise testing services for a wide range of products. The tests are carried out in accordance with the required National and International Standards such as ISO, ASTM, IS, BS, APHA, etc.
Spectro has years of experience in this field and has maintained its reliability and integrity. Be it routine testing or product compliance certification, Spectro helps you get your product to the marketplace on time and with all the quality assurance you need to promote and sell it. Apart from testing we also provide Inspection Services, Calibration Services, Lab Training and Project Consultancy.By using our testing services, you can be sure about the reduced risk and greater performance of your raw materials, components and products.
Our team gets you through the entire process of getting the right quality assurance for your product with timely, accurate and reliable services to keep you moving forward with your business goals.
Spectro offers a complete range of material testing services. Our range of services is quite considerable. Metals, Building Materials, Raw and Cooked Food, Water, Minerals and ores, Welded Structures, Hazardous Substances, Drugs and Cosmetics, Petroleum Products, Paints & Coatings, Wood and Furniture, Leather and Textiles, Paper, Electrical and Electronic Products, Rubbers and Polymers, Refractory Materials are just to name a few.
Our specialized tests include Fire Testing, ROHS & REACH, Failure Analysis, Non Destructive Testing, Cleanroom Validation, Radiation Monitoring, HACCP, and many more.